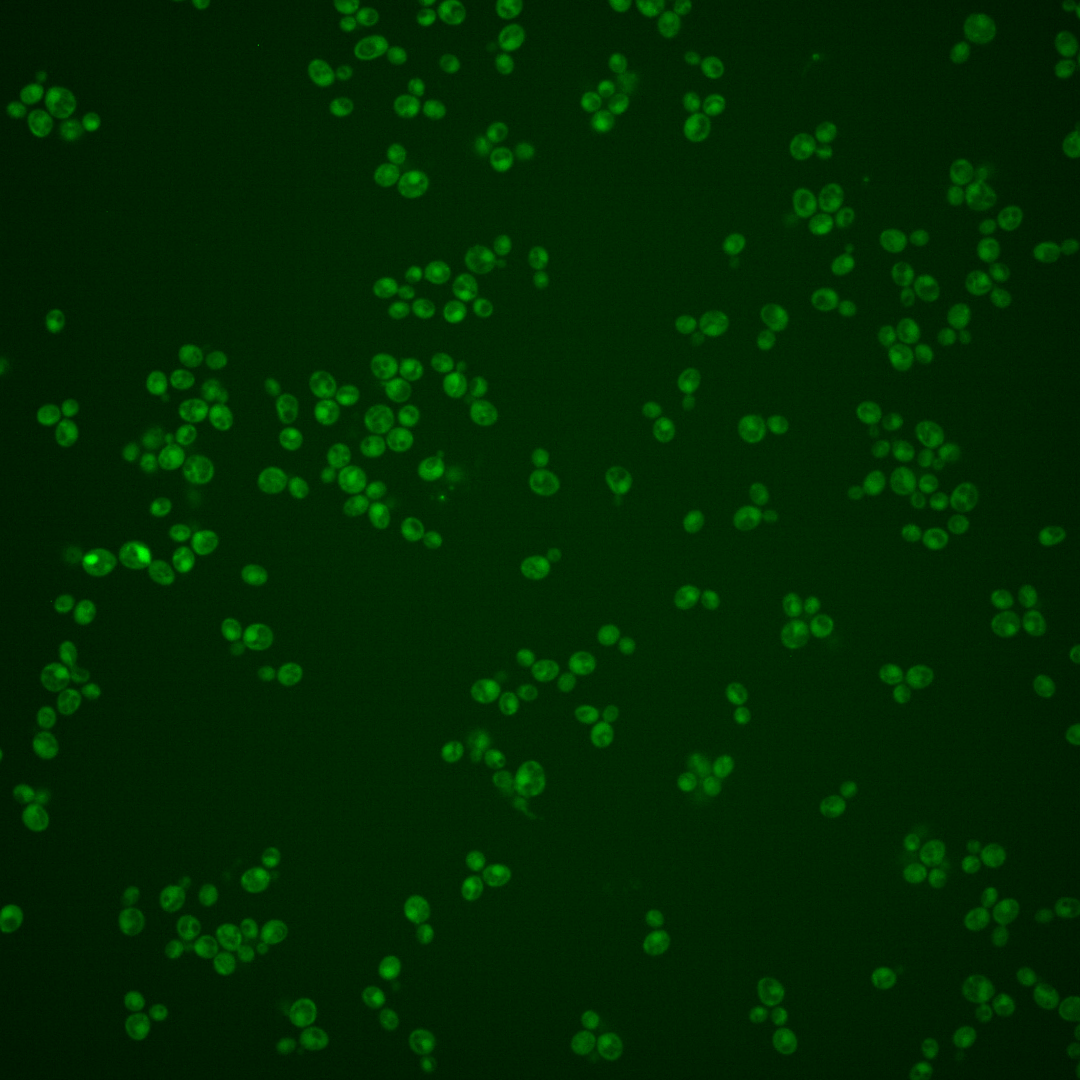
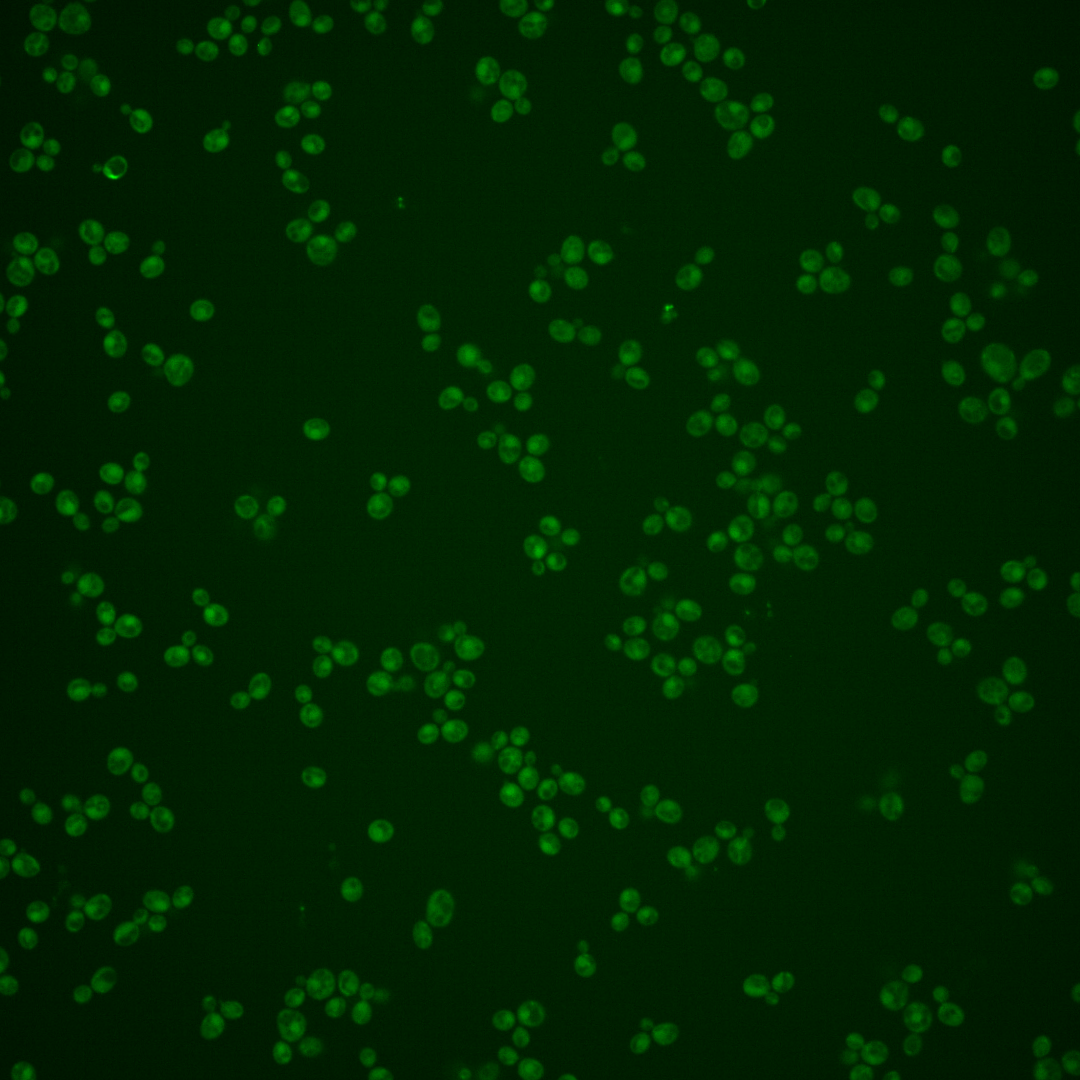
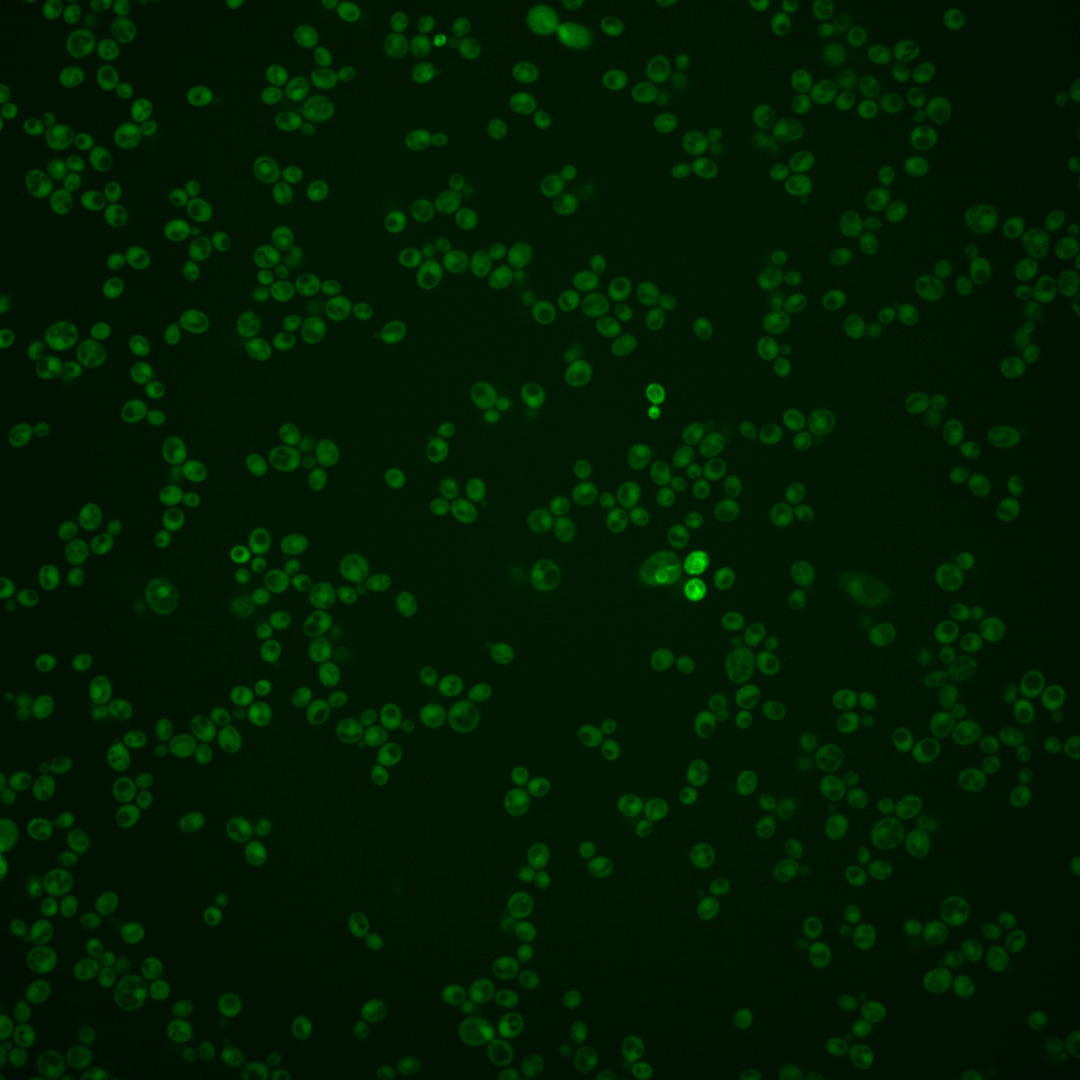
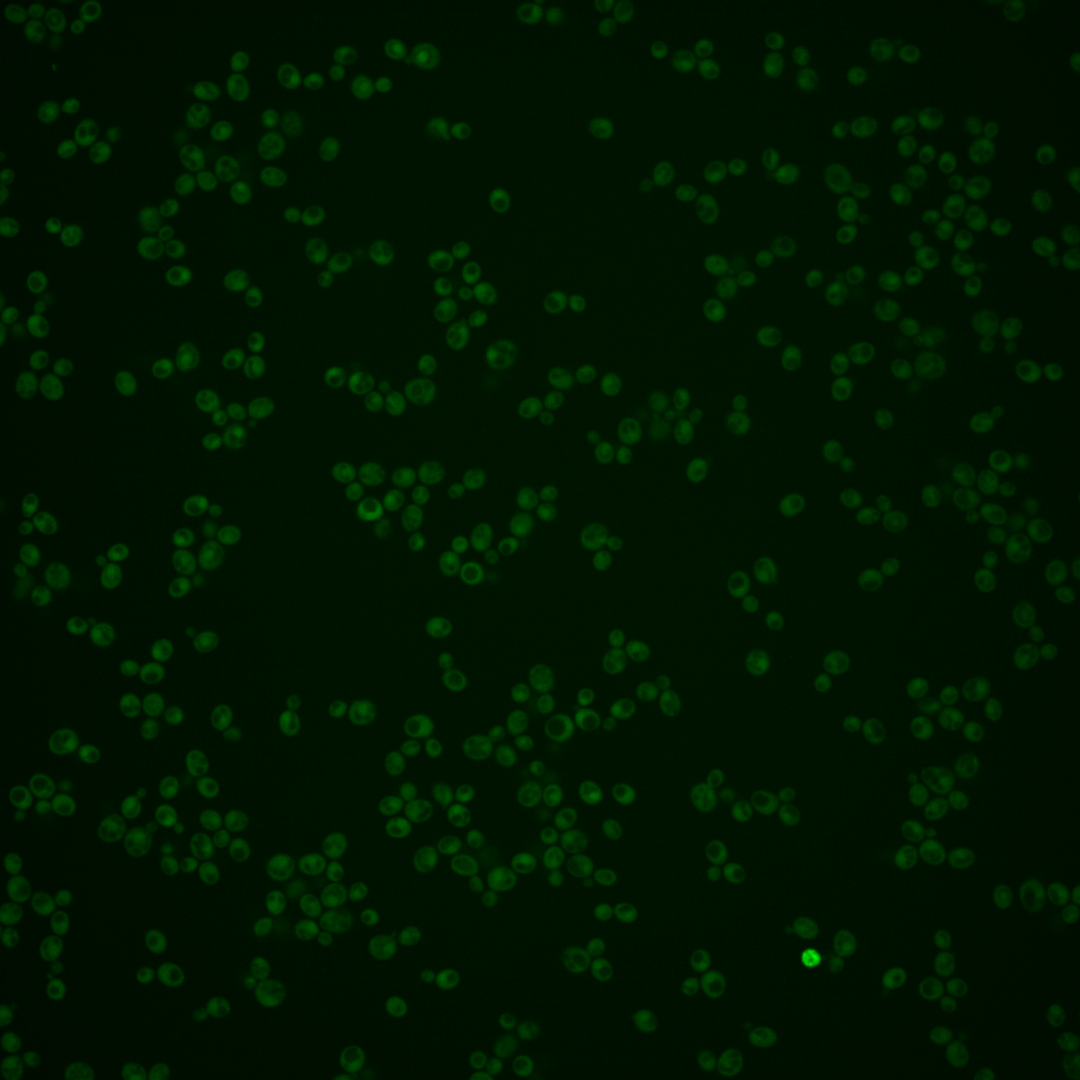

| Standard name | |
|---|---|
| Human Ortholog | |
| Description | m(7)GpppX pyrophosphatase regulator; non-essential, stress induced regulatory protein; modulates m7G-oligoribonucleotide metabolism; inhibits Dcs1p; regulated by Msn2p, Msn4p, and the Ras-cAMP-cAPK signaling pathway; mutant has increased aneuploidy tolerance; DCS2 has a paralog, DCS1, that arose from the whole genome duplication |
Micrographs




















































































Sub-cellular Localization
Yeast GFP Assignment
Protein Abundance
Localization Change
External localization resources
| ensLOC | DeepLoc | |||||||||||||||||||||||
|---|---|---|---|---|---|---|---|---|---|---|---|---|---|---|---|---|---|---|---|---|---|---|---|---|
| Localization | WT1 | WT2 | WT3 | RAP60 | RAP140 | RAP220 | RAP300 | RAP380 | RAP460 | RAP540 | RAP620 | RAP700 | HU80 | HU120 | HU160 | rpd3Δ_1 | rpd3Δ_2 | rpd3Δ_3 | WT1 | WT2 | WT3 | AF100 | AF140 | AF180 |
| Cortical Patches | 0 | 0 | 0 | 0 | 0 | 0 | 0 | 0 | 0 | 1 | 0 | 0 | 0 | 0 | 0 | 0 | 1 | – | 1 | 1 | 2 | 0 | 0 | 0 |
| Bud | 0 | 2 | 1 | 3 | 1 | 4 | 19 | 10 | 10 | 11 | 9 | 12 | 0 | 0 | 0 | 1 | 0 | – | 0 | 0 | 1 | 0 | 2 | 2 |
| Bud Neck | 0 | 0 | 1 | 0 | 1 | 1 | 2 | 1 | 0 | 1 | 0 | 0 | 0 | 0 | 0 | 0 | 1 | – | 0 | 0 | 0 | 0 | 0 | 1 |
| Bud Site | 0 | 0 | 0 | 0 | 0 | 0 | 0 | 2 | 2 | 3 | 3 | 3 | 0 | 0 | 0 | 0 | 0 | – | – | – | – | – | – | – |
| Cell Periphery | 0 | 0 | 1 | 1 | 1 | 1 | 0 | 5 | 1 | 2 | 3 | 4 | 0 | 0 | 3 | 2 | 2 | – | 0 | 0 | 1 | 0 | 0 | 0 |
| Cytoplasm | 112 | 131 | 193 | 264 | 365 | 317 | 481 | 457 | 160 | 264 | 129 | 233 | 228 | 300 | 353 | 35 | 37 | – | 119 | 133 | 161 | 40 | 231 | 231 |
| Endoplasmic Reticulum | 1 | 0 | 1 | 2 | 0 | 0 | 1 | 1 | 0 | 1 | 1 | 2 | 0 | 1 | 3 | 1 | 0 | – | 1 | 0 | 2 | 0 | 0 | 0 |
| Endosome | 0 | 0 | 1 | 2 | 1 | 6 | 1 | 2 | 3 | 1 | 0 | 0 | 2 | 0 | 2 | 1 | 1 | – | 2 | 0 | 2 | 0 | 1 | 1 |
| Golgi | 0 | 0 | 0 | 1 | 0 | 0 | 0 | 0 | 0 | 0 | 0 | 0 | 0 | 0 | 0 | 0 | 0 | – | 0 | 0 | 1 | 0 | 0 | 0 |
| Mitochondria | 33 | 3 | 1 | 16 | 18 | 91 | 229 | 187 | 105 | 154 | 118 | 128 | 0 | 0 | 0 | 2 | 0 | – | 14 | 3 | 16 | 0 | 0 | 2 |
| Nucleus | 0 | 2 | 0 | 0 | 1 | 4 | 14 | 15 | 14 | 21 | 7 | 12 | 0 | 1 | 1 | 0 | 0 | – | 0 | 0 | 0 | 0 | 1 | 1 |
| Nuclear Periphery | 1 | 1 | 0 | 0 | 0 | 0 | 6 | 15 | 6 | 3 | 7 | 11 | 0 | 0 | 0 | 0 | 0 | – | 0 | 0 | 0 | 0 | 0 | 0 |
| Nucleolus | 0 | 0 | 0 | 1 | 0 | 0 | 0 | 0 | 0 | 0 | 0 | 2 | 0 | 0 | 0 | 0 | 0 | – | 0 | 0 | 0 | 0 | 0 | 0 |
| Peroxisomes | 0 | 0 | 1 | 0 | 0 | 0 | 0 | 0 | 0 | 0 | 0 | 0 | 0 | 0 | 0 | 0 | 0 | – | 0 | 0 | 0 | 0 | 0 | 0 |
| SpindlePole | 0 | 0 | 1 | 1 | 2 | 3 | 6 | 6 | 3 | 4 | 1 | 3 | 0 | 0 | 0 | 0 | 1 | – | 1 | 0 | 2 | 0 | 1 | 2 |
| Vac/Vac Membrane | 0 | 1 | 1 | 3 | 4 | 8 | 25 | 63 | 21 | 40 | 33 | 47 | 0 | 1 | 1 | 1 | 2 | – | 3 | 2 | 1 | 0 | 1 | 2 |
| Unique Cell Count | 133 | 135 | 199 | 277 | 379 | 364 | 620 | 624 | 259 | 395 | 239 | 364 | 230 | 300 | 359 | 37 | 41 | 148 | 148 | 199 | 42 | 243 | 251 | |
| Labelled Cell Count | 147 | 140 | 202 | 294 | 394 | 435 | 784 | 764 | 325 | 506 | 311 | 457 | 230 | 303 | 363 | 43 | 45 | 148 | 148 | 199 | 42 | 243 | 251 | |
Yeast GFP Assignment
Protein Abundance
| Screen | WT1 | WT2 | WT3 | RAP60 | RAP140 | RAP220 | RAP300 | RAP380 | RAP460 | RAP540 | RAP620 | RAP700 | HU80 | HU120 | HU160 | rpd3Δ_1 | rpd3Δ_2 | rpd3Δ_3 | AF100 | AF140 | AF180 |
|---|---|---|---|---|---|---|---|---|---|---|---|---|---|---|---|---|---|---|---|---|---|
| Mean Cell GFP Intensity (1e-4) | 3.3 | 3.9 | 4.3 | 4.1 | 4.2 | 3.7 | 3.7 | 4.1 | 4.6 | 5.0 | 5.5 | 5.9 | 5.5 | 6.2 | 5.4 | 6.3 | 7.1 | – | 5.2 | 6.0 | 6.3 |
| Std Deviation (1e-4) | 0.4 | 0.9 | 1.4 | 2.1 | 2.2 | 2.1 | 1.8 | 2.2 | 3.0 | 3.1 | 3.7 | 3.9 | 1.2 | 9.0 | 1.3 | 1.5 | 2.9 | – | 0.5 | 1.5 | 1.6 |
| Intensity Change (Log2) | – | – | – | -0.07 | -0.03 | -0.22 | -0.2 | -0.05 | 0.11 | 0.21 | 0.36 | 0.47 | 0.35 | 0.53 | 0.34 | 0.55 | 0.72 | – | 0.27 | 0.48 | 0.55 |
Localization Change
| Localization | RAP60 | RAP140 | RAP220 | RAP300 | RAP380 | RAP460 | RAP540 | RAP620 | RAP700 | HU80 | HU120 | HU160 | rpd3Δ_1 | rpd3Δ_2 | rpd3Δ_3 |
|---|---|---|---|---|---|---|---|---|---|---|---|---|---|---|---|
| Actin | – | – | – | – | – | – | – | – | – | – | – | – | – | – | – |
| Bud | – | – | – | – | – | – | – | – | – | – | – | – | – | – | – |
| Bud Neck | – | – | – | – | – | – | – | – | – | – | – | – | – | – | – |
| Bud Site | – | – | – | – | – | – | – | – | – | – | – | – | – | – | – |
| Cell Periphery | – | – | – | – | – | – | – | – | – | – | – | – | – | – | – |
| Cyto | – | – | – | – | – | – | – | – | – | – | – | – | – | – | – |
| Endoplasmic Reticulum | – | – | – | – | – | – | – | – | – | – | – | – | – | – | – |
| Endosome | – | – | – | – | – | – | – | – | – | – | – | – | – | – | – |
| Golgi | – | – | – | – | – | – | – | – | – | – | – | – | – | – | – |
| Mitochondria | – | – | – | – | – | – | – | – | – | – | – | – | – | – | – |
| Nuclear Periphery | – | – | – | – | – | – | – | – | – | – | – | – | – | – | – |
| Nuc | – | – | – | – | – | – | – | – | – | – | – | – | – | – | – |
| Nucleolus | – | – | – | – | – | – | – | – | – | – | – | – | – | – | – |
| Peroxisomes | – | – | – | – | – | – | – | – | – | – | – | – | – | – | – |
| SpindlePole | – | – | – | – | – | – | – | – | – | – | – | – | – | – | – |
| Vac | – | – | – | – | – | – | – | – | – | – | – | – | – | – | – |
| Cortical Patches | – | – | – | – | – | – | – | – | – | – | – | – | – | – | – |
| Cytoplasm | – | – | – | – | – | – | – | – | – | – | – | – | – | – | – |
| Nucleus | – | – | – | – | – | – | – | – | – | – | – | – | – | – | – |
| Vacuole | – | – | – | – | – | – | – | – | – | – | – | – | – | – | – |
External localization resources
Images






























Protein Concentration and Protein Localization Data
| R1 | R2 | R3 | ||||||||||||||||
|---|---|---|---|---|---|---|---|---|---|---|---|---|---|---|---|---|---|---|
| G1 Pre-START | G1 Post-START | S/G2 | Metaphase | Anaphase | Telophase | G1 Pre-START | G1 Post-START | S/G2 | Metaphase | Anaphase | Telophase | G1 Pre-START | G1 Post-START | S/G2 | Metaphase | Anaphase | Telophase | |
| Concentration | 1.6131 | 0.7309 | 1.0526 | 0.9385 | 2.0845 | 1.2004 | -0.9127 | -0.2837 | -0.261 | -0.5618 | -0.6874 | -0.3503 | -1.7904 | -1.3169 | -1.7519 | -1.1548 | -1.7202 | -1.1626 |
| Actin | 0.0563 | 0.001 | 0.0303 | 0.0003 | 0.0493 | 0.0131 | 0.0436 | 0.0002 | 0.024 | 0.0037 | 0.0002 | 0.0096 | 0.017 | 0.0003 | 0.0052 | 0.0027 | 0.0014 | 0.0102 |
| Bud | 0.0081 | 0.0021 | 0.0018 | 0.009 | 0.0078 | 0.0019 | 0.0011 | 0.0006 | 0.002 | 0.0008 | 0.0001 | 0.0003 | 0.0004 | 0.0039 | 0.0026 | 0.0115 | 0.0001 | 0.0066 |
| Bud Neck | 0.0136 | 0.0004 | 0.0097 | 0.0003 | 0.0042 | 0.0141 | 0.0013 | 0.0001 | 0.0008 | 0.0002 | 0.0001 | 0.001 | 0.0008 | 0.0001 | 0.0018 | 0.0037 | 0.0001 | 0.0009 |
| Bud Periphery | 0.0157 | 0.0054 | 0.0028 | 0.0129 | 0.0193 | 0.0034 | 0.0014 | 0.0019 | 0.0014 | 0.0005 | 0 | 0.0004 | 0.0004 | 0.0084 | 0.0022 | 0.013 | 0.0001 | 0.0138 |
| Bud Site | 0.0175 | 0.0077 | 0.0112 | 0.0035 | 0.0082 | 0.0013 | 0.0018 | 0.0011 | 0.0125 | 0.0002 | 0 | 0.0006 | 0.0056 | 0.0051 | 0.0101 | 0.0159 | 0.0001 | 0.0021 |
| Cell Periphery | 0.0022 | 0.0002 | 0.0005 | 0.0005 | 0.0005 | 0.0002 | 0.0003 | 0.0002 | 0.0003 | 0.0001 | 0 | 0.0001 | 0.0002 | 0.0002 | 0.0001 | 0.0002 | 0 | 0.0002 |
| Cytoplasm | 0.1442 | 0.1563 | 0.1437 | 0.3081 | 0.1232 | 0.2439 | 0.3928 | 0.5775 | 0.5414 | 0.6351 | 0.6779 | 0.6751 | 0.1718 | 0.3027 | 0.233 | 0.3578 | 0.2764 | 0.4118 |
| Cytoplasmic Foci | 0.0272 | 0.0038 | 0.0131 | 0.0072 | 0.0498 | 0.0164 | 0.0447 | 0.0057 | 0.0397 | 0.006 | 0.0039 | 0.0347 | 0.0202 | 0.007 | 0.0108 | 0.0299 | 0.0241 | 0.0146 |
| Eisosomes | 0.0006 | 0.0002 | 0.0004 | 0.0001 | 0.0013 | 0.0004 | 0.0002 | 0 | 0.0001 | 0 | 0 | 0.0001 | 0.0008 | 0.0001 | 0.0001 | 0.0001 | 0 | 0.0001 |
| Endoplasmic Reticulum | 0.0089 | 0.0005 | 0.0026 | 0.0013 | 0.0044 | 0.0027 | 0.0055 | 0.0027 | 0.0043 | 0.006 | 0.0019 | 0.0022 | 0.0017 | 0.0037 | 0.0012 | 0.0018 | 0.0008 | 0.0049 |
| Endosome | 0.0292 | 0.0004 | 0.0072 | 0.0015 | 0.0217 | 0.0121 | 0.0306 | 0.0032 | 0.0344 | 0.006 | 0.0012 | 0.0124 | 0.0147 | 0.0022 | 0.0033 | 0.0106 | 0.0072 | 0.018 |
| Golgi | 0.0108 | 0.0001 | 0.0049 | 0.0002 | 0.0064 | 0.0036 | 0.0077 | 0.0002 | 0.0116 | 0.0005 | 0.0001 | 0.0113 | 0.0082 | 0.0001 | 0.0027 | 0.008 | 0.01 | 0.0114 |
| Lipid Particles | 0.007 | 0.0001 | 0.0034 | 0.0004 | 0.0135 | 0.0045 | 0.0283 | 0.0002 | 0.0059 | 0.0007 | 0 | 0.0102 | 0.0168 | 0.0023 | 0.0025 | 0.0028 | 0.0021 | 0.0059 |
| Mitochondria | 0.0079 | 0.0007 | 0.01 | 0.0014 | 0.0087 | 0.01 | 0.0037 | 0.0002 | 0.0096 | 0.0007 | 0.0001 | 0.004 | 0.0083 | 0.0002 | 0.001 | 0.0014 | 0.0027 | 0.0099 |
| None | 0.6023 | 0.8172 | 0.736 | 0.6425 | 0.5333 | 0.6452 | 0.4004 | 0.4012 | 0.2882 | 0.3325 | 0.3123 | 0.2293 | 0.7069 | 0.659 | 0.7169 | 0.5306 | 0.6165 | 0.4729 |
| Nuclear Periphery | 0.0126 | 0.0002 | 0.0082 | 0.0007 | 0.0268 | 0.0057 | 0.0054 | 0.0008 | 0.0027 | 0.0013 | 0.0004 | 0.0015 | 0.0014 | 0.0011 | 0.0004 | 0.001 | 0.0003 | 0.0077 |
| Nucleolus | 0.0014 | 0.0002 | 0.001 | 0.0008 | 0.0039 | 0.0006 | 0.002 | 0.0001 | 0.0007 | 0 | 0 | 0.0001 | 0.0009 | 0.0002 | 0.0002 | 0.0003 | 0 | 0.0004 |
| Nucleus | 0.0151 | 0.001 | 0.0039 | 0.0025 | 0.0298 | 0.0042 | 0.0018 | 0.001 | 0.0021 | 0.0012 | 0.001 | 0.001 | 0.0012 | 0.0009 | 0.0014 | 0.0019 | 0.0003 | 0.0013 |
| Peroxisomes | 0.0065 | 0.0012 | 0.0031 | 0.0004 | 0.0606 | 0.0035 | 0.0184 | 0.0001 | 0.0092 | 0.0001 | 0 | 0.0024 | 0.0122 | 0.0002 | 0.0016 | 0.0029 | 0.0561 | 0.0019 |
| Punctate Nuclear | 0.0066 | 0.0006 | 0.0045 | 0.0009 | 0.0226 | 0.0072 | 0.0053 | 0.0005 | 0.0023 | 0.0003 | 0.0002 | 0.002 | 0.0073 | 0.001 | 0.0021 | 0.0011 | 0.0003 | 0.0027 |
| Vacuole | 0.0046 | 0.0005 | 0.001 | 0.0049 | 0.0026 | 0.0041 | 0.0028 | 0.0023 | 0.0054 | 0.0036 | 0.0005 | 0.001 | 0.0025 | 0.0012 | 0.0006 | 0.0022 | 0.0011 | 0.0021 |
| Vacuole Periphery | 0.0018 | 0 | 0.0006 | 0.0006 | 0.0022 | 0.0017 | 0.0009 | 0.0002 | 0.0014 | 0.0005 | 0.0001 | 0.0005 | 0.0005 | 0.0001 | 0.0001 | 0.0004 | 0.0002 | 0.0009 |
Sequencing Data
| R1 | R2 | |||||||||
|---|---|---|---|---|---|---|---|---|---|---|
| G1 Post-START | S/G2 | Metaphase | Anaphase | Telophase | G1 Post-START | S/G2 | Metaphase | Anaphase | Telophase | |
| Gene Expression | 2.5975 | 4.644 | 6.2028 | 5.6473 | 3.3677 | 9.3457 | 6.1041 | 7.9229 | 9.4293 | 6.0762 |
| Translational Efficiency | – | – | – | – | – | – | – | – | – | – |
Hit Data
| Dataset | Hit |
|---|---|
| Protein Concentration | ✘ |
| Protein Localization | ✘ |
| Gene Expression | ✘ |
| Translational Efficiency | – |
Endocytosis
| Temp | Actin Patch (Sac6-tdTomato) | Cortical Patch (Sla1-GFP) | Late Endosome (Snf7-GFP) | Vacuole (Vph1-GFP) |
|---|---|---|---|---|
| 37℃ | ||||
| RT |
Cell Cycle Omics
CYCLoPs (Dcs2-GFP)
| Gene / Allele | Actin Patch (Sac6-tdTomato) | Cortical Patch (Sla1-GFP) | Late Endosome (Snf7-GFP) | Vacuole (Sac6-tdTomato) |
|---|
| Gene | Images |
|---|
| Gene | Images |
|---|
Images are not yet available
Images are not yet available